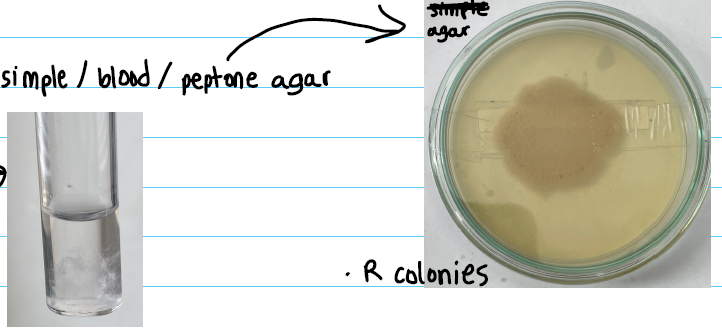
<p><strong>simple / blood / peptone agar:</strong></p><ul><li><p>round</p></li><li><p>no hemolysis</p></li></ul><p></p><p><strong>simple broth:</strong></p><ul><li><p>cotton like sediment</p></li></ul><p></p>

1/7
Group 20 2025
Name | Mastery | Learn | Test | Matching | Spaced | Call with Kai |
|---|
No analytics yet
Send a link to your students to track their progress
Morphology
Rods
bamboo tree, long chains
Capsule
SPORE forming
Staining
Gram +
Pathogenic factor
Exotoxins
Cultivation
simple / blood / peptone agar:
round
no hemolysis
simple broth:
cotton like sediment
Specimen
Secretion of Malignant pustules
blood
Symptoms
cutanous:
Itchy Papule
Visicle - ulcer
Black malignant pustule
Inhalation:
first flu like symptoms
hemorrhagic mediastinitis
shock - cyanosis
GI- Anthrax:
severe abdominal pain
Nausea, vomiting
bloody diarrhea
fever
Antibiotics
Penicillin
Doxycyclin
Vaccine
Live attenuated vaccine